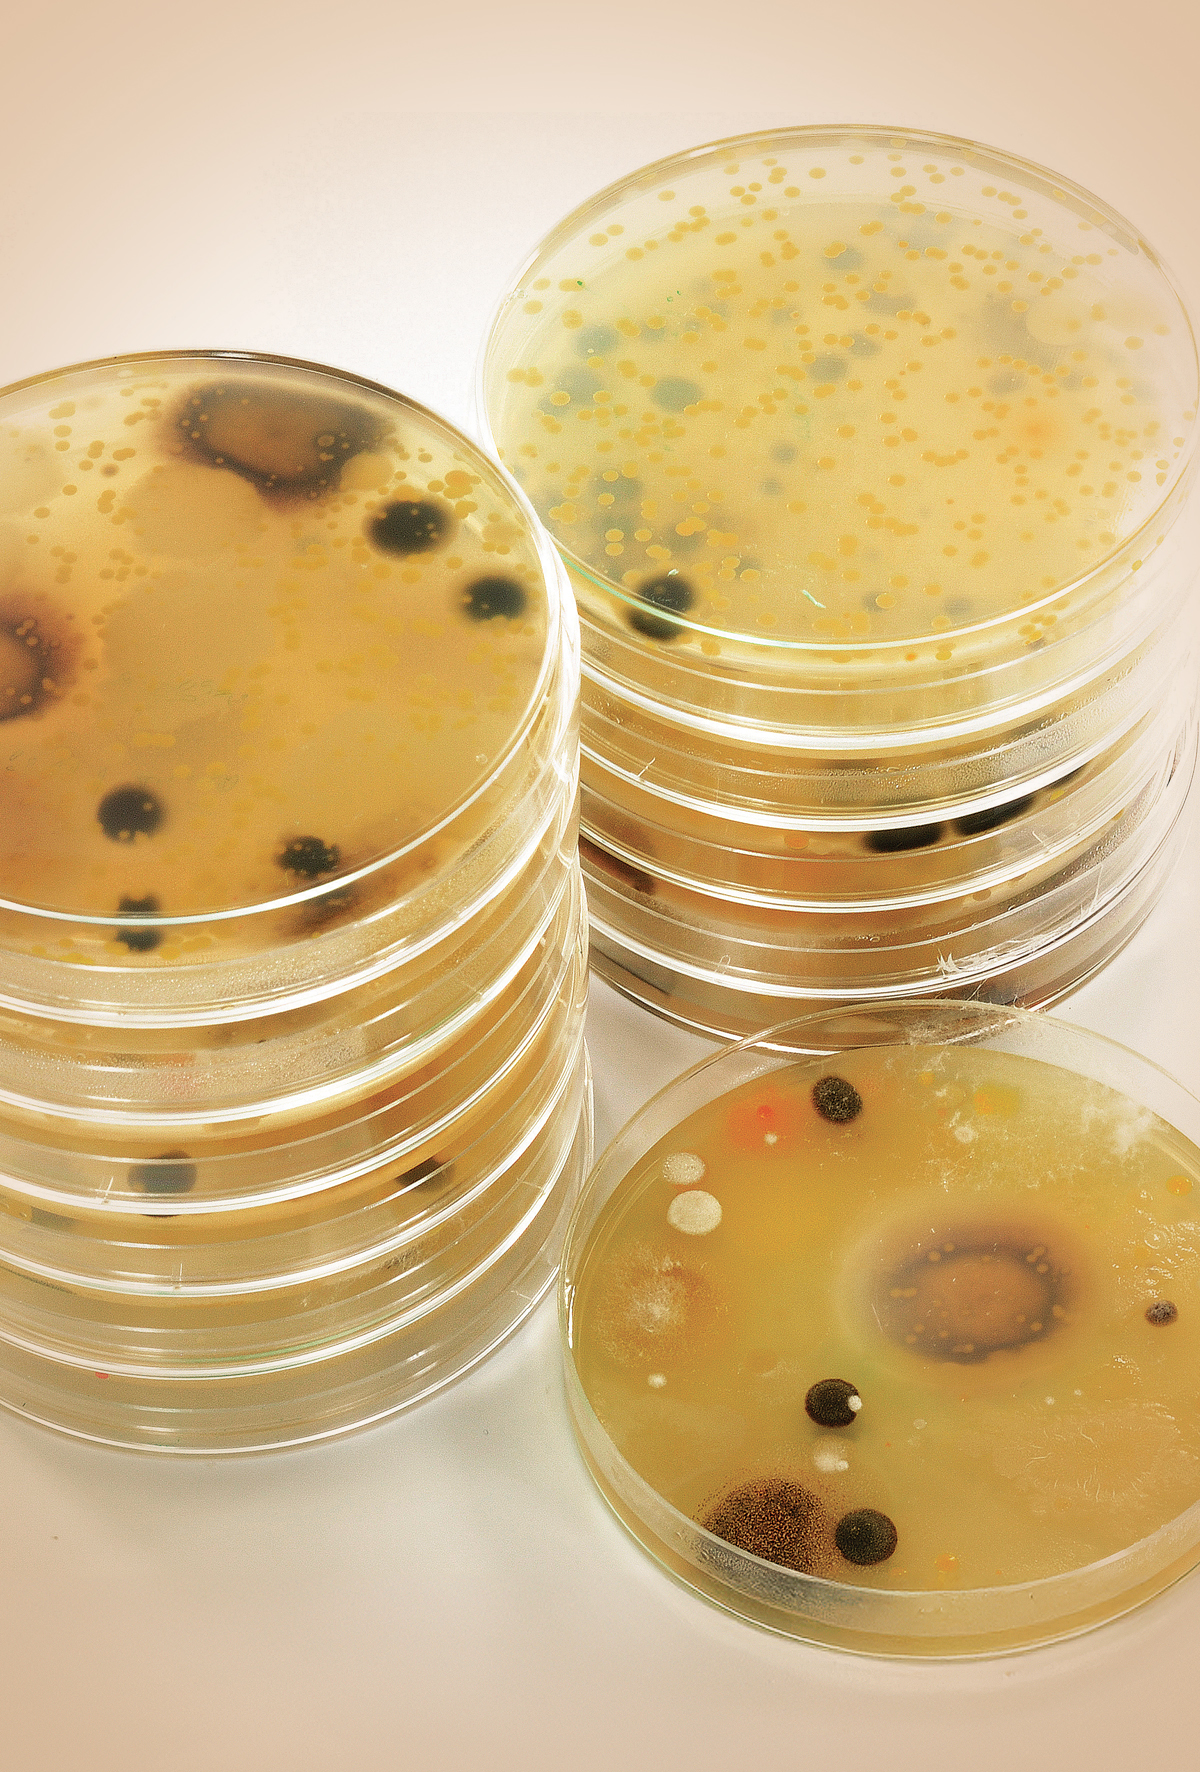
Asya’da mikotoksin alarmı

Asya’da mikotoksin alarmı
DSM-Firmenich’in 2025 ilk çeyreğine ait küresel mikotoksin araştırmasına göre, Çin ve Güney Asya’da yem örneklerinin %94’ünde mikotoksin tespit edildi.
DSM-Firmenich’in 2025 ilk çeyreğine ait küresel mikotoksin araştırmasına göre, Çin ve Güney Asya’da yem örneklerinin %94’ünde mikotoksin tespit edildi.
İçeriği görüntüleyebilmek için lütfen şifre girişi yapın.